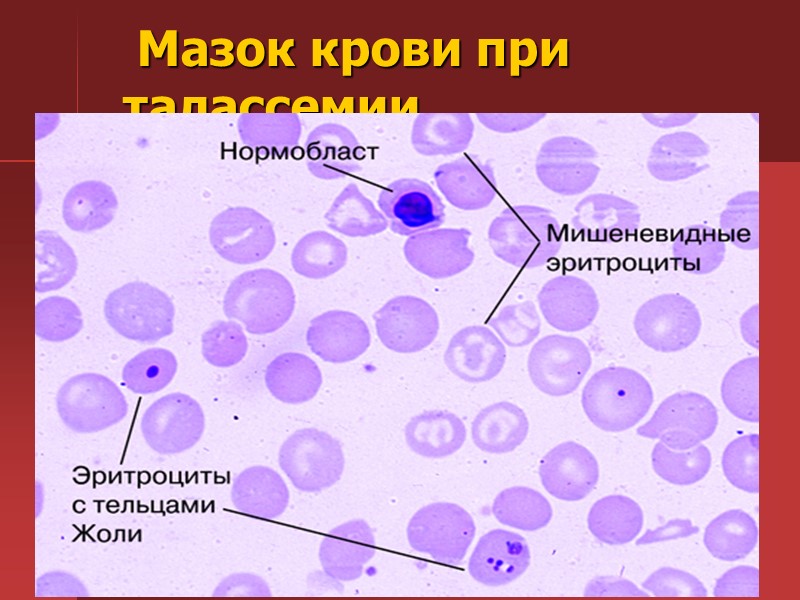
Картина крови при таллассемии (в поле зрения характерные мишеневидные эритроциты Картина крови при таллассемии (в поле зрения характерные мишеневидные эритроциты

Анемии. Витамин В12 дефицитная, апластическая, гемолитическая анемии. Мультимедийный

72-differencialynaya_diagnostika_anemiy_novaya.ppt
- Количество слайдов: 102
Анемии. Витамин В12 дефицитная, апластическая, гемолитическая анемии. Мультимедийный атлас к практическим занятиям у студентов 5 курса лечебного факультета
Различные формы эритроцитов. а, б — анизоцитоз, пойкилоцитоз, эритроциты с тельцами Жолли; в — лептоциты; г-дрепаноциты; д — эллиптоциты; е — микросфероциты.
Изменение формы эритроцитов
Изменение формы эритроцитов
Изменение формы эритроцитов
Изменение формы эритроцитов
Изменение формы эритроцитов
Изменение формы эритроцитов
Изменение формы эритроцитов
Изменение окраски эритроцитов
Изменение окраски эритроцитов
Изменение окраски эритроцитов
Включения в эритроцитах
Включения в эритроцитах
Включения в эритроцитах
Включения в эритроцитах
Мазок нормальной крови
Морфология клеток эритроцитарного ряда. а - Эритробласт; б — пронормобласт; в — нормобласт базофильный; г — нормобласт полихроматофильный; д—нормобласт оксифильный; е — эритроциты с ядерными дериватами (тельца Жолли)
АНЕМИЯ — состояние, характеризующееся уменьшением гемоглобина в единице объема крови за счет снижения его общего количества в организме. В большинстве случаев анемия сопровождается также снижением числа эритроцитов в единице объема крови. От истинной анемии следует отличать гидремию — разжижение крови за счет тканевой жидкости
В основе развития анемии лежат различные патологические процессы в связи с чем выделяют по патогенезу следующие группы: железодефицитные; 1.сидероахрестические (железонасыщенные); 2.В12-дефицитные и фолиеводефицитные; 3.гемолитические; 4.анемии, обусловленные нарушением пролиферации клеток костного мозга; 5.анемии со смешанным механизмом развития.
Проявления анемий чрезвычайно разнообразны и определяются: 1) патогенетическим вариантом анемии; 2) этиологией; 3) изменениями в организме, обусловленными реакцией организма на гипоксию органов и тканей, вызванную нарушением дыхательной функции крови (доставка кислорода тканям) — циркуляторно-гипоксическим синдромом. Этот синдром проявляется слабостью, повышенной утомляемостью, одышкой при физической нагрузке, сердцебиениями, «анемическим» шумом в крупных сосудах, увеличением объема циркулирующей крови, ускорением кровотока. Циркуляторно-гипоксический синдром наблюдается в большей или меньшей степени при всех видах анемических состояний; выраженность его зависит от степени гипоксии, что в свою очередь определяется кислородной емкостью крови (иначе говоря, выраженностью анемического состояния
Сущность железодефицитной анемии (ЖДА) состоит в нехватке железа в организме (истощение запасов железа в органах-депо), вследствие чего нарушается синтез гемоглобина; поэтому каждый эритроцит содержит меньше гемоглобина, чем в норме. ЖДА встречаются чаще всех остальных форм анемий, что объясняется множеством причин, ведущих к дефициту железа в организме.
Основные причины дефицита железа Кровотечения: а) маточные (дисфункция яичников, фибромиома матки, рак шейки матки, эндометриоз и др.); б) желудочно-кишечные (язвенная болезнь, геморрой, рак, диафрагмальная грыжа, неспецифичский язвенный колит, полипоз); в) легочные (рак, бронхоэктазы, изолированный легочный гемосидероз). Повышенный расход железа: а) беременность, лактация; б) период роста и полового созревания; в) хронические инфекции, опухоли. Нарушение всасывания железа: а) резекция желудка; б) энтерит, спру. Нарушение транспорта железа. Врожденный дефицит железа (этот механизм возможен при 5КДА у матери во время беременности).
Клиническая картина. Проявление болезни, как это вытекает из схемы патогенеза, складывается из следующих синдромов: 1.циркуляторно-гипоксического (при выраженной анемии и кислородном голодании тканей); 2.поражения эпителиальных тканей (гастроэнтерологические расстройства, трофические нарушения кожи и ее дериватов); 3.гематологического (анемия гипохромного типа и признаки дефицита железа).
Имеет значение стадия течения анемии. 1.Скрытый дефицит железа, проявляющийся снижением уровня сывороточного железа при нормальном содержании гемоглобина в анализе периферической крови. 2.Тканевый сидеропенический синдром (проявляется желудочно-кишечными расстройствами, трофическими изменениями кожи и ее дериватов). 3.Анемия (снижение уровня гемоглобина).
Диагностика. При постановке диагноза ЖДА выделяют два этапа: Доказательство дефицита железа в организме (как причины анемии); Выявление причин железодефицитного состояния. Критериями дефицита железа и анемии являются гемоглобин ниже 120 г/л у мужчин и ниже 116 г/л у женщин, снижение цветового показателя (ниже 0,86); среднего содержания гемоглобина в эритроцитах (24 пг); средней концентрации гемоглобина в эритроцитах (ниже 30 %); повышение количества микроцитов (эритроцитов диаметром менее 6 мкм) более 20 %; снижение содержания сывороточного железа (норма у мужчин 12—32 мкмоль/л, у женщин — 12—25 мкмоль/л); повышение содержания свободного трансферрина — более 35,8 мкмоль/л и общего трансферрина (ОЖСС) при норме 54—72 мкмоль/л; снижение насыщения трансферрина железом (менее 25 %); повышение всасывания радиоактивности железа; положительная десфераловая проба (уменьшение содержания железа в моче после введения десферала).
Ярко-красный язык и заеды в углах рта при анемии
Патология ногтей, развивающаяся при длительно существующем дефиците железа: так называемые "койлонихии" - ложкообразные ногти. Линии Beau у женщины, страдающей железодефицитной анемией
Для установления причины железодефицитного состояния прежде всего необходимо найти источник кровотечения. Для этого наряду с тщательным клиническим обследованием необходимо проведение эндоскопических (ЭГДС, ректоромано- и колоноскопия, бронхоскопия) и других методов исследования. Женщин обязательно должен осмотреть гинеколог. Обнаружить скрытые (оккультные) кровотечения очень трудно. Если не удалось выявить источник кровотечения, то применяют пробу с введением больному его собственных эритроцитов, предварительно меченных 51Сг, а в последующем определяют радиоактивность кала. Высокая радиоактивность свидетельствует об источнике кровотечения в пищеварительном тракте. При хронических инфекциях важное значение имеет определение уровня свободного трансферрина сыворотки (латентная железосвязывающая способность сыворотки), который в отличие от постгеморрагических анемий остается нормальным.
Воздействуют на этиологические факторы (удаление источника кровотечения, санация очагов инфекции, противоопухолевая терапия, профилактика врожденного дефицита железа) и проводят патогенетическую терапию (ликвидация дефицита железа, восстановление нарушений гемодинамики).
Восстановление резерва железа осуществляется приемом лекарственных препаратов железа внутрь (или парентерально). Необходимо, чтобы суточная доза двухвалентного железа (всасывается только двухвалентное железо) составляла 100—300 мг. В связи с этим при выборе препарата железа и определении его суточной дозы необходимо ориентироваться не только на общее содержание в нем железа, но и на количество двухвалентного железа. Естественно, что предпочтительнее назначать препараты с высоким содержанием двухвалентного железа в связи с удобством их приема (1—2 раза в сутки). Входящие в состав многих лекарственных форм аскорбиновая и янтарная кислоты, фруктоза, цистеин усиливают всасывание железа. Для лучшей всасываемости препараты железа следует принимать до еды.
У ряда больных приходится применять парентеральные препараты железа; показаниями являются: тошнота, рвота (непереносимость препаратов железа при приеме внутрь, что не позволяет продолжать дальнейшее лечение); нарушение всасывания при патологии кишечника (энтериты, резекция тонкого кишечника, синдром недостаточного всасывания); нежелательность назначения внутрь препаратов железа больным с патологией желудочно-кишечного тракта (обострение язвенной болезни желудка или двенадцатиперстной кишки, болезнь Крона, неспецифический язвенный колит); необходимость более быстрого насыщения организма железом (особенно в ситуациях, когда планируется хирургическое вмешательство по тому или иному поводу).
Сидероахрестическая анемия (САА) — железонасыщенная, или сидеро-бластная, анемия, при которой эритроциты содержат мало железа (гипо-хромны) вследствие неиспользования его костным мозгом для синтеза гемоглобина.
Этиология и патогенез. В основе развития сидероахрестических анемий лежит нарушение синтеза гема. Железо, белок, необходимые для синтеза гемоглобина, имеются, однако отсутствует достаточное количество протопорфирина. Вследствие этого не осуществляется синтез гема — основного компонента молекулы гемоглобина. Гем — соединение порфириновых колец (протопорфирина) с атомом железа. Гем, соединяясь с глобином, образует молекулу гемоглобина. При САА уменьшается образование порфиринов и возникает избыток железа. Уменьшение образования порфиринов обусловлено врожденным или приобретенным дефицитом ряда ферментов. Накопление железа в организме приводит к отложению его во внутренних органах.
Выделяют две основные наследственные формы САА: пиридоксинзависимую (дефицит пиридоксальфосфата, поэтому назначение пиридоксина — витамина В6 — эффективно) и пиридоксинрезистентную (эта форма встречается крайне редко). Имеется непосредственный ферментный дефект (дефицит гемсинтетазы, обеспечивающей включение железа в молекулу гема). Приобретенные формы чаще наблюдаются в пожилом возрасте, заболевание не носит семейного характера. САА чаще возникает при лечении ту-беркулостатическими препаратами (тубазид) вследствие истощения запасов пиридоксальфосфата, при свинцовой интоксикации, алкоголизме, кожной порфирии, миелопролиферативных заболеваниях крови. Могут быть также идиопатические формы САА.
. На I этапе диагностического поиска выявляются жалобы, обусловленные гипоксически-циркуляторным синдромом. В анамнезе — указания на бледность, слабость, увеличение печени и селезенки. Дети быстро устают, плохо учатся, у них плохая память; у взрослых — слабость, снижение толерантности к физической нагрузке, возникающие после длительного лечения основного заболевания (туберкулеза), профессиональных вредностей (контакт со свинцом). Можно обнаружить сведения о выявлении низких показателей гемоглобина и неуспешном лечении препаратами железа.
На II этапе диагностического поиска в периоды обострения возможно выявление бледности кожных покровов и видимых слизистых оболочек, У части больных — увеличение печени и селезенки в умеренных пределах.
III этап диагностического поиска. Лабораторные исследования выявляют снижение гемоглобина в сочетании с низким цветовым показателем, нормальное или повышенное количество ретикулоцитов. В сыворотке крови определяют высокое содержание железа, а в пунктате костного мозга — повышенное количество сидеробластов (клетки костного мозга с включениями железа в виде гранул). Дефицит ферментов, участвующих в обмене порфиринов, уточняют путем определения продуктов порфиринов в моче. Повышенное содержание железа в организме доказывается также с помощью десфераловой пробы (после введения десферала с мочой выделяется увеличенное количество железа). При биопсии печени, селезенки можно обнаружить признаки гемосидероза. ОЖСС у таких больных снижена.
Лечение. Назначение препаратов железа неэффективно, увеличивает содержание железа в крови и способствует гемосидерозу органов. Точно так же не показаны и гемотрансфузии. Применяется пиридоксин (витамин Вб) в дозах 50—200 мг/сут внутрь или по 100 мг внутримышечно 2 раза в неделю в течение 2 мес. Наиболее эффективен кофермент пиридоксальфосфат, так как иногда бывает блокирована возможность перехода пиридоксина в пиридоксальфосфат. При наследственных формах лечение витамином В6 надо повторять периодически.
Для уменьшения гемосидероза органов и снижения уровня сывороточного железа назначают десферал (внутривенно по 500—1000 мг) с перерывами, ориентируясь на уровень железа и присутствие сидеробластов в костном мозге.
Включения в эритроцитах
Гемолитические анемии (ГА) составляют обширную группу заболеваний, значительно различающихся по этиологии, патогенезу, клинической картине и лечению. Основным патологическим процессом, объединяющим эти заболевания в одну группу, является повышенный гемолиз. Гемолиз может происходить внутриклеточно (в макрофагах селезенки, как обычный физиологический), так и непосредственно в сосудах (внутрисосудистый или внеклеточный). В норме продолжительность жизни эритроцита составляет 100—120 дней, а при гемолитических анемиях она сокращается до 12—14 дней.
Повышенный гемолиз в крови увеличивается содержание свободного (непрямого) билирубина, с чем связано желтушное окрашивание кожи и слизистых оболочек, выраженное в различной степени; избыточное количество непрямого билирубина перерабатывается гепатоцитами в прямой билирубин, вследствие чего желчь интенсивно окрашивается (плейохромия) и возникает склонность к образованию камней в желчном пузыре и протоках; в кишечнике, куда поступает желчь, образуются в увеличенном количестве стеркобилиноген и уробилиноген, в связи с чем каловые массы интенсивно окрашены; в моче увеличивается содержание уробилина; общее количество эритроцитов уменьшается, увеличивается количество ретикулоцитов в периферической крови, а также содержание эритробластов и нормоцитов в костном мозге. Проявления повышенного гемолиза, происходящего в сосудах: в крови увеличивается количество свободного гемоглобина; свободный гемоглобин выделяется с мочой в неизмененном виде или в виде гемосидерина (моча при этом имеет красный, бурый или почти черный цвет); гемосидерин может откладываться во внутренних органах (гемосидероз).
Наследственные ГА: 1.связанные с нарушением мембраны эритроцитов (гемолитическая микросфероцитарная анемия, или болезнь Минковского—Шоффара, овалоиитоз, стоматоцитоз); 2. связанные с нарушением активности ферментов в эритроцитах [глю-козо-6-фосфатдегидрогеназа (Г-6-ФД), пируваткиназа, глутатион-редуктазаи др.]; 3)связанные с нарушением структуры или синтеза цепей глобина (талассемия, серповидно-клеточная анемия и др.).
Приобретенные ГА: 1.связанные с воздействием антител (изоиммунные, аутоиммунные); 2.связанные с изменением структуры мембраны эритроцитов вследствие соматической мутации (пароксизмальная ночная гемоглобинурия, или болезнь Маркиафавы—Микели); 3.связанные с механическим повреждением мембраны эритроцита (протезы клапанов сердца, маршевая гемоглобинурия); 4.обусловленные химическими повреждениями эритроиитов (гемолитические яды, свинец, тяжелые металлы, органические кислоты); 5. обусловленные недостатком витамина Е; 6.связанные с воздействием паразитов (малярия).
Желтушное прокрашивание кожи и склер при гемолитической анемии различной этиологии
Наследственный микросфероцитоз (болезнь Минковского—Шоффара) спленомегалия; камни в желчном пузыре; гиперрегенераторная анемия и желтуха в период криза; микросфероциты в мазке крови; снижение осмотической резистентности эритроцитов после инкубации цельной крови в стерильных условиях в течение суток при температуре 37 "С в случаях, когда количество сфероцитов больше 1—2 % от общего количества эритроцитов. повышение уровня спонтанного гемолиза после 49-часового инкубирования крови в стерильных условиях до 10—50 % (в норме лизируется менее 4 %).
Изменение формы эритроцитов
Талассемия Бета-талассемия протекает в двух вариантах: 1) большая талассемия (анемия Кули), наблюдающаяся в детском возрасте (гомозиготная форма); 2) малая талассемия, встречающаяся у взрослых (гетерозиготная форма)
Диагностика талассемии Выраженная гемолитическая анемия с гипохромными микроцитарными эритроцитами. Анизоцитоз, множество мишеневидных эритроцитов, а также каплеи сигарообразные эритроциты в мазке периферической крови. Повышение фракции гемоглобина HbF, отсутствие фракции НЬА. 4. Может иметь место повышение фракции НЬА2 почти вдвое.
Мазок крови при талассемии
Картина крови при таллассемии (в поле зрения характерные мишеневидные эритроциты — кодоциты).
Лечение талассемии гемотрансфузии + прием десферала (во избежание развития гемосидероза); фолиевая кислота по 0,005 г 1—2 раза в день при снижении уровня гемоглобина в связи с инфекционными заболеваниями, при беременности; витамины группы В (В6, В,2), С для улучшения эритропоэза (хотя подобное назначение небесспорно); спленэктомия при значительной спленомегалии и распаде в ней эритроцитов.
Аутоиммунная гемолитическая анемия симптоматическую форму (анемия развивается на фоне какого-то определенного заболевания: гемобластоза, системного заболевания соединительной ткани, хронического активного гепатита, опухоли, неспецифического язвенного колита и пр.); идиопатическую форму, когда выявить определенное заболевание не удается (острая инфекция, беременность, роды и травма в анамнезе не являются причиной АИГА, а лишь провоцируют ее обострение).
Аутоиммунная гемолитическая анемия
Проявления АИГА в достаточной степени полиморфны и обусловлены: 1) быстротой развития гемолиза (кризовое течение или более «спокойное»); 2) преобладающим патогенетическим механизмом гемолиза (те или иные аутоантитела вызывают гемолиз при различных внешних условиях: холод, тепло и др.); 3) изменением органов (в частности, печени и селезенки); 4) местом, где происходит гемолиз (селезенка, сосудистое русло); 5) фоновыми заболеваниями (при вторичных АИГА).
В период криза средством выбора являются кортикостероидные гормоны, которые всегда прекращают или уменьшают гемолиз. В острой фазе назначают большие дозы преднизолона (60—90 мг/сут) или эквивалентные дозы других ГКС. При наступлении ремиссии дозу постепенно уменьшают, переводя больного на поддерживающие дозы (5—10 мг/сут). Длительность гормональной терапии составляет 2—3 мес при проведении гематологического и серологического контроля (до исчезновения или существенного уменьшения количества аутоантител).
Пароксизмальная ночная гемоглобинурия (ПНГ), называемая также болезнью Маркиафавы—Микели, представляет собой приобретенную гемолитическую анемию с постоянным внутрисосудистым гемолизом и выделением с мочой гемосидерина.
Клиническая картина. Проявления болезни определяются выраженностью внутрисосудистого гемолиза, а также возникновением множественных тромбозов мелких сосудов (мезентериальных, верхних и нижних конечностей, а также почечных, мозговых, сосудов селезенки). Предполагается, что склонность к тромбозам, отмечаемая в периоды гемолитических кризов, обусловлена высвобождением при гемолизе эритроцитов (в особенности ретикулоцитов) большого количества веществ, обладающих тромбофилической активностью.
ДИАГНОСТИКА Общий анализ крови помогает установить снижение показателей гемоглобина и числа эритроцитов. В период обострения болезни содержание гемоглобина существенно снижается (до 30—50 г/л), повышаясь до нормы в период ремиссии. Содержание эритроцитов снижается соответственно снижению гемоглобина, поэтому цветовой показатель долго остается близким к 1,0. Если больной теряет с мочой много железа (в виде гемоглобина и гемосидерина), то цветовой показатель снижается. Содержание ретикулоцитов повышено умеренно (до 2—4 %). Количество лейкоцитов чаще бывает умеренно снижено, тромбоцитов — нормальное или умеренно сниженное. Исследование костного мозга выявляет в основном признаки гемолитической анемии — раздражение красного ростка при нормальном количестве миелокариоцитов. Содержание железа в сыворотке крови снижается вследствие постоянной и частой гемоглобинурии, когда гемосидерин постоянно обнаруживается в моче. Однако снижение содержания железа не является признаком пнг. Уровень билирубина повышается в большинстве случаев нерезко или сохраняется нормальным. Нарушение структуры оболочки эритроцита хорошо выявляется с помощью пробы Хэма (кислотная проба) и сахарозной пробы. При пробе Хэма эритроциты больного гемолизируются в свежей подкисленной сыворотке (нормальные эритроциты не гемолизируются), при сахарозной пробе гемолиз эритроцитов происходит при добавлении к сыворотке сахарозы.
. Патогенетических методов лечения ПНГ не существует. Тяжесть анемии обусловливается интенсивностью гемолиза и ответной реакцией эритроидного ростка. При анемии целесообразно переливание эритроцитов, предварительно отмытых трижды изотоническим раствором хлорида натрия. Такие эритроциты переливают 1 раз в 4—5 дней в дозе 200—400 мл. Многие больные нуждаются в таких переливаниях в течение нескольких месяцев. В последнее время стали применять препараты, обладающие антиоксидантным действием, способствующие стабилизации мембраны эритроцитов. Препарат витамина Е назначают в дозе 3—4 мг/сут. Препараты железа показаны при его значительной потере и выраженном дефиците. Для борьбы с тромбозами применяют гепарин, чаще в небольших дозах (5000 ЕД 2—3 раза в день под кожу живота), а также антикоагулянты непрямого действия.
Сущность В12-дефицитной анемии (В12ДЦА) состоит в нарушении образования дезоксирибонуклеиновой кислоты (ДНК) в связи с нехваткой в организме витамина В12 (цианокобаламина), что приводит к нарушению кроветворения, появлению в костном мозге мегалобластов, внутрикостномозговому разрушению эритрокариоцитов, снижению количества эритроцитов и гемоглобина, лейкопении, нейтропении и тромбоцитопении, а также к изменению ряда органов и систем (пищеварительный тракт, ЦНС).
Этиология. 1) нарушением секреции гастромукопротеина («внутренний фактор») при наследственно обусловленной атрофии желез желудка (пернициозная анемия, или болезнь Аддисона—Бирмера), при органических заболеваниях Желудка (полипоз, рак), после гастрэктомии; 2) повышением расхода витамина В]2 (инвазия широкого лентеца, активация кишечной микрофлоры при дивертикулезах тонкой кишки); нарушением всасывания витамина В12 (органические заболевания кишечника — спру, илеит, рак, состояние после резекции кишки, наследственное нарушение всасывания — болезнь Имерслунд—Гресбека); нарушением транспорта витамина В12 (дефицит транскобаламина)- образованием антител к «внутреннему фактору» или комплексу «внутренний фактор» + витамин В12.
ПАТОГЕНЕЗ В12-ДЕФИЦИТНОЙ АНЕМИИ
Клиника В12-дефицитной анемии складывается из: 1) циркуляторно-гипоксического (при достаточной выраженности анемии и кислородного голодания тканей); 2) гастроэнтерологического; 3) неврологического; 4) гематологического (анемия гиперхромного типа).
Критерии диагноза 1) снижение содержания эритроцитов (менее 3,0-1012/л); 2) повышение цветового показателя (более 1,1); 3) повышение содержания гемоглобина в эритроцитах (более 34 пг); 4) увеличение среднего объема эритроцита (более 120 мкм3); 5) сдвиг эритроцитометрической кривой вправо (увеличение количества макроцитов, появление мегалоцитов — эритроцитов диаметром более 12 мкм); 6) появление в мазках пунктата костного мозга элементов мегалобластного кроветворения; 7)повышение содержания сывороточного железа (более 30,4 мкмоль/л); 8)снижение радиоактивности мочи после приема витамина В,2, меченного радиоактивным кобальтом.
Для выявления причины анемии следует проводить рентгенологическое и эндоскопическое исследование пищеварительного тракта (опухоль желудка, дивертикулез тонкой кишки), гельминтологическое исследование (инвазия широким лентецом), функциональное исследование печени с биопсией (хронический гепатит, цирроз), исследование нейтрального жира в кишечнике (спру).
Комплекс лечебных мероприятий при В12ДА следует проводить с учетом: 1)этиологии, 2)выраженности анемии и неврологических нарушений.
Патогенетическая терапия осуществляется с помощью парентерального введения витамина В12 (ликвидация его дефицита), а также нормализации измененных показателей центральной гемодинамики и нейтрализации антител к гастромукопротеину («внутреннему фактору») или комплексу гастромукопротеин + витамин В12 (кортикостероидная терапия). Цианокобаламин (витамин В12) вводят ежедневно внутримышечно в дозе 200—500 мкг 1 раз в день в течение 4—6 нед до наступления гематологической ремиссии.
Критериями гематологической реакции являются резкое Увеличение количества ретикулоцитов в периферической крови — ретикулоцитарный криз, трансформация мегалобластического кроветворения в Нормобластическое. Появление ретикулоцитарного криза на 5—6-й день лечения является ранним критерием его эффективности. В процессе лечения цианокобаламином количество эритроцитов нарастает быстрее, чем содержание гемоглобина, в связи с этим цветовой показатель обычно снижается. После нормализации костномозгового кроветворения и состава Крови (обычно через 1,5—2 мес) витамин В,2 вводят 1 раз в неделю в течение 2—3 мес, затем в течение полугода 2 раза в месяц в тех же дозах
Мазки крови при В12-дефицитной анемии
Картина крови при пернициозной анемии. В поле зрения мегалобласт, макроциты (мегалоциты), эритроциты с ядерными дериватами (кольца Кебота, тельца Жолли) и базофильной зернистостью, шизоциты, пойкилоцитоз, полисегментоядерный нейтрофил.
Мегалобласты в костном мозге при пернициозной анемии.
Пунктат костного мозга при гемолитической анемии. (преобладают базофильные и полихромафильные нормобласты).
Сущность гипопластической (и апластической) анемии состоит в резком угнетении костномозгового кроветворения, что сопровождается снижением числа эритроцитов, лейкоцитов и тромбоцитов. Известна также парциальная форма гипопластической анемии с угнетением образования только эритроцитов.
К резкому угнетению костномозгового кроветворения приводят различные причины: 1.внешние факторы, оказывающие миелотоксическое действие (инфекционные заболевания, ионизирующая радиация, цитостатические препараты, различные химические вещества, лекарственные средства); 2.внутренние причины (эндогенные): влияние токсичных веществ при уремии, гипотиреозе и др.;аутоагрессия и появление антител к кроветворным клеткам; 3.идиопатические формы, когда не удается выявить никаких причин
Согласно международным критериям, принято выделять две основные формы АА. Критериями тяжелой формы являются содержание нейтрофилов в периферической крови менее 0,5 Х109/л, тромбоцитов — менее 20 Х109/л, ретикулоцитов — менее 10%о ; при исследовании костного мозга отмечается выраженное снижение клеточности или умеренная гипоплазия с количеством гемопоэтических клеток менее 30 %. Если показатели периферической крови соответствуют хотя бы двум критериям, а результаты исследования костного мозга — одному, то можно поставить диагноз тяжелой формы АА. При нетяжелой форме болезни прогноз намного лучше (все перечисленные показатели изменены существенно меньше).
Три основных синдрома: цитопенический, септико-некротический и геморрагический.
Лечение АА — непростая задача, она должна включать: 1.ликвидацию (или хотя бы ограничение) контакта больного с лицами, страдающими инфекционными заболеваниями (в том числе и неспецифическими); 2.устранение воздействия этиологического фактора (например, лекарственных или химических средств, если доказана связь между их приемом и развитием болезни); 3.трансфузионную терапию; 4.спленэктомию; 5.введение антитимоцитарного иммуноглобулина (тимоглобулин); 6.ГКС и циклоспорин; 7.трансплантацию костного мозга

